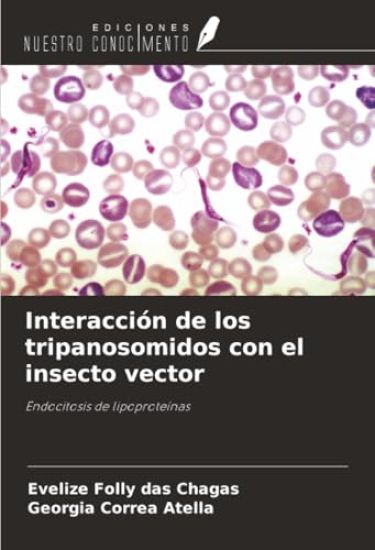
Interacción de los tripanosomidos con el insecto vector

The essential reference book on matrices--now fully updated and expanded, with new material on scalar and vector mathematics Since its initial publication, this book has become the essential reference for users of matrices in all branches of engineering, science, and applied mathematics. In this revised and expanded edition, Dennis Bernstein combines extensive material on scalar and vector mathematics with the latest results in matrix theory to make this the most comprehensive, current, and easy-to-use book on the subject. Each chapter describes relevant theoretical background followed by specialized results. Hundreds of identities, inequalities, and facts are stated clearly and rigorously, with cross-references, citations to the literature, and helpful comments. Beginning with preliminaries on sets, logic, relations, and functions, this unique compendium covers all the major topics in matrix theory, such as transformations and decompositions, polynomial matrices, generalized inverses, and norms. Additional topics include graphs, groups, convex functions, polynomials, and linear systems. The book also features a wealth of new material on scalar inequalities, geometry, combinatorics, series, integrals, and more. Now more comprehensive than ever, Scalar, Vector, and Matrix Mathematics includes a detailed list of symbols, a summary of notation and conventions, an extensive bibliography and author index with page references, and an exhaustive subject index. * Fully updated and expanded with new material on scalar and vector mathematics* Covers the latest results in matrix theory* Provides a list of symbols and a summary of conventions for easy and precise use* Includes an extensive bibliography with back-referencing plus an author index